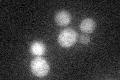
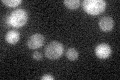

View description
Non-essential protein of unknown function with structural resemblance to plant storage and ligand binding proteins (canavalin, glycinin, auxin binding protein) and to some enzymes (epimerase, germin); localizes to the nucleus and cytoplasm
Localization:
Intensity:
Fold change:
Significance:
-
C’ GFP library in SD
cytosol27.55 -
N' NOP1pr-GFP in SD

cytosol227.95 -
N' TEF2pr-mCherry in SD

cytosol403.382 -
N' NATIVEpr-GFP in SD

ambiguous23.121 -
N' TEF2pr-VC and Cyto-VN in SD

cytosol78.3952 -
C’ GFP library in SD+DTT

cytosol23.740.86No -
C’ GFP library in SD+H2O2

cytosol24.450.88No -
C’ GFP library in Starvation Media
cytosol25.470.92No -
C’ GFP library on the background of Pup2-DaMP

cytosol -
C’ GFP library on the background of CCT mutant

cytosol26.87150.975021No
